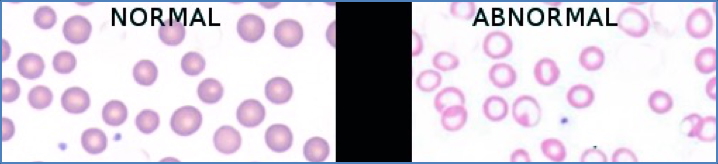
Iron Deficiency Anaemia

Table of Contents
Overview – Iron Deficiency Anaemia
Iron deficiency anaemia (IDA) is the most common type of anaemia worldwide and a major global health concern. It typically results from chronic blood loss, increased physiological demand, or inadequate iron intake and absorption. Iron is critical for haemoglobin production, and its deficiency leads to microcytic, hypochromic red cells. Early recognition and treatment are essential to prevent complications and improve oxygen delivery to tissues.
Definition
- Anaemia due to insufficient iron for adequate haemoglobin synthesis
- Results in microcytic, hypochromic red cells
- Most common cause of anaemia globally
Aetiology
1. Chronic Blood Loss (most common cause)
- Gastrointestinal bleeding (ulcers, cancer, NSAIDs)
- Menorrhagia
- Parasitic infections (e.g. hookworm)
2. Increased Demand
- Pregnancy
- Growth spurts in children and adolescents
3. Poor Intake or Absorption
- Malnutrition (low intake of meat or leafy greens)
- Malabsorption (e.g. coeliac disease, gastric bypass, atrophic gastritis)
Pathophysiology
- Iron is a core component of haemoglobin
- Deficiency impairs haemoglobin synthesis → reduced red cell production
- Marrow compensates by producing smaller and less haemoglobin-rich RBCs
Morphology – Blood Film
- Microcytic (low MCV)
- Hypochromic (pale, low haemoglobin content)
- Anisocytosis – variation in RBC size
- Poikilocytosis – variation in RBC shape
- Pencil cells – elongated, narrow RBCs with one pointed end
Clinical Features
Symptoms
- Fatigue
- Headache, dizziness
- Exertional dyspnoea and angina
- Claudication in elderly
- Worsening of cardiorespiratory conditions
General Signs
- Pallor (mucosal, palmar, facial)
- Tachycardia
- Systolic flow murmur
- Signs of high-output cardiac failure (e.g. peripheral oedema)
Iron-Deficiency Specific Signs
- Atrophic glossitis (smooth, inflamed tongue)
- Angular chelitis (painful fissures at mouth corners)
- Koilonychia (spoon-shaped nails)
- Brittle nails and hair
Investigations
Full Blood Count
- ↓ Hb
- ↓ MCV
- ↓ MCH
- Blood film: microcytosis, hypochromia, anisopoikilocytosis, pencil cells
Iron Studies
- ↓ Serum iron
- ↓ Ferritin
- ↑ Total Iron Binding Capacity (TIBC)
Differentials for Microcytic Anaemia
- Thalassaemia
- Anaemia of chronic disease
- Sideroblastic anaemia (rare)
Management
- Oral iron supplementation (e.g. ferrous sulfate)
- Address underlying cause (e.g. treat bleeding lesion, improve diet)
- Monitor response: reticulocyte count ↑ within a week; Hb ↑ by 10g/L/week
Summary – Iron Deficiency Anaemia
Iron deficiency anaemia is a microcytic, hypochromic anaemia typically caused by chronic blood loss, dietary insufficiency, or malabsorption. It presents with both general anaemia symptoms and iron-specific features such as glossitis and koilonychia. Diagnosis is based on blood film and iron studies, and treatment involves iron supplementation and correcting the underlying cause. For a broader context, see our Blood & Haematology Overview page.